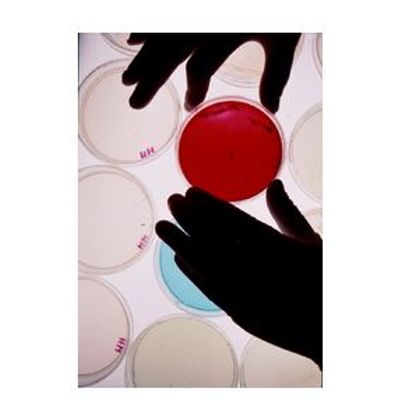

- Home
- Companies
- Alvim Srl
- Applications
- Biofilm Sensor for Legionella ...
Biofilm Sensor for Legionella Prevention - Manufacturing, Other
Even when it has not been created by pathogenic bacteria, biofilm is the ideal environment for the survival and growth of pathogens, includingLegionella pneumophila. It is well known that such bacteria do not usually form biofilms by themselves, but they are commonly found in biofilms made by other bacteria. This kind of environment greatly increases Legionella possibility of survival and growth. Thus, the best way to prevent Legionella outbreaks is limiting biofilm development.
This Hospital measured, by means of water sampling and laboratory analyses, high levels ofLegionella pneumophila(up to 2500 CFU per litre) inside its water lines. The possible threat was made even worse by the fact that also the Maternity Ward of the Hospital was interested by such problem. Therefore, the staff in charge of water lines sanitation decided to apply a new biocide treatment (24/7, low dosage), and to install an ALVIM sensor in the Maternity Ward pipeline. The new treatment helped to drastically reduce Legionella presence in the water system, but the ALVIM sensor showed that biofilm was still alive and growing, possibly representing a shelter for Legionella survival. The laboratory analysis (heterotrophic plate count), carried out on swabs taken from the ALVIM surface and the surrounding pipeline, confirmed the presence of bacterial biofilm.
Thanks to the ALVIM technology, it was possible to see that the improved results provided by the new sanitation treatment could be considered only a first step towards the complete eradication of Legionella risk inside the Hospital’s water system. Indeed, only keeping biofilm growth under control it is possible to maintain the risk of Legionella outbreaks as low as possible.
